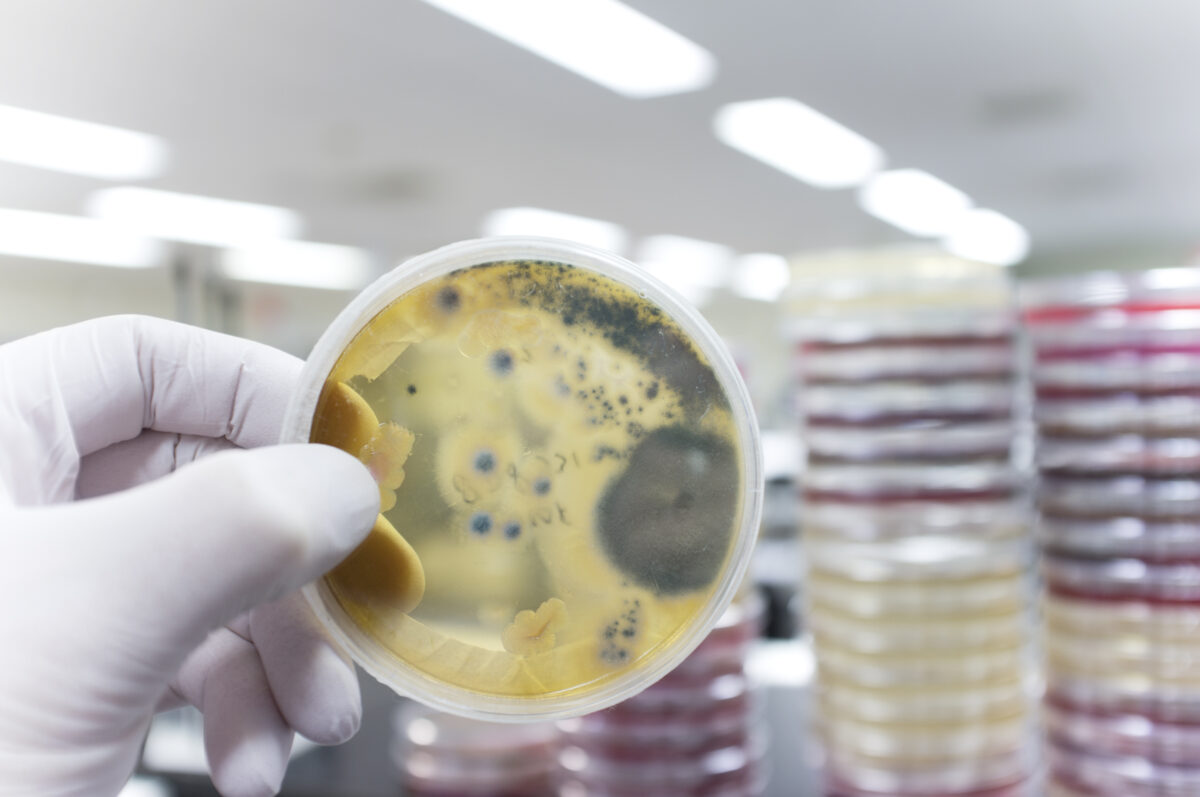
A hand with a medical glove is holding a agar plate with a culture of pathogenic fungi.

Cupron Performance Additives offers the breadth of copper-based benefits across form factors and substrate chemistries.
Cupron builds upon its medical roots to offer “ready-to-use” products across manufacturing environments. Copper itself is an indispensable micronutrient which provides critical functions such as cell respiration, neurotransmitter synthesis, and collagen and elastin formation in skin.